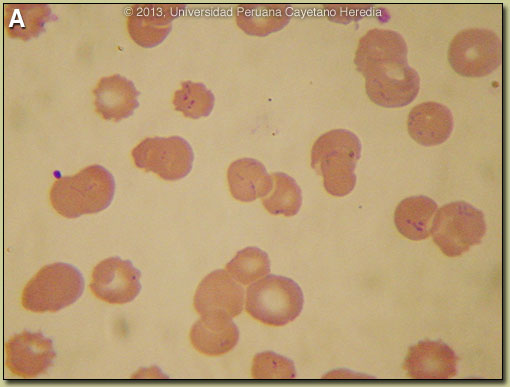
Image A for 03/11/2013

![]() |
2013 Case #6 | ![]() |
| Diagnosis: Acute bartonellosis due to Bartonella bacilliformis. |
|
Clinically the acute phase of infection follows an average 20-day incubation period but can be as long as 100 days. Almost all patients have fever, malaise, and anorexia. Pallor is usually noticeable, in hospitalized cases anyway, as the average admission hematocrit is 17%. The anemia is due to red-cell lysis and not autoimmune in nature as the Coombs test is uniformly negative. Hepatomegaly, lymphadenopathy, and jaundice each occur in about ¾ of cases but splenomegaly in only about ¼. A significant number of patients may develop congestive heart failure, pericardial effusion, or anasarca. Neurologic complications of uncertain etiology occur in about 20%; manifestations include altered mental status, ataxia, agitation, or even coma. Bartonella bacilliformis has only rarely been isolated in culture from these patients. Overall mortality of patients with neurologic manifestations is over 50% and altered mental status on hospital admission is correlated with mortality. The severe septic form manifested by this patient with pulmonary, hemolytic, and hepatic abnormalities is unusual but we have shown one similar case before [see Gorgas Case 2007-08]. A secondary immunosuppression may lead to subsequent or concomitant salmonellosis (both S. typhi and non typhi); toxoplasma reactivation and occasionally other opportunistic infections have been seen. In those untreated patients that have unapparent acute phases or survive the primary infection, a chronic eruptive phase occurs. Skin lesions, called Verruga Peruana, are most commonly miliary in nature with multiple 1-4 mm papular, erythematous round lesions that are often pruritic [see Gorgas Case 2005-08]. These are loaded with bacteria and are histologically similar to HIV-related bacillary angiomatosis lesions caused by the related organisms Bartonella henselae and Bartonella quintana. Bartonella henselae is also the agent of cat-scratch disease. The distribution of Bartonella bacilliformis, which is transmitted by the bite of the Lutzomyia verrucarum sandfly is restricted to the inter-Andean valleys of Perú and Ecuador. The railway between Lima and La Oroya high in the Andes was one of the engineering feats of the 19th century, but thousands of workers died of bartonellosis during construction (hence the name Oroya Fever). Classically, transmission was thought to be restricted to 500-2500 meters elevation and between 2-13 degrees latitude in these two countries, but more recently cases have been described up to 3200 meters. Caras is one of the best-known hyperendemic foci. A review of the epidemiology and other aspects of bartonellosis has recently been published [PLoS Negl Trop Dis. 2012;6(10):e1819]. Travelers are more likely to encounter bartonellosis when trekking out of Huaraz in the Cordillera Blanca region of the country. In vitro data confirm that B. bacilliformis is sensitive to most antibiotics including penicillins (including Penicillin G and ampicillin), cephalosporins, aminoglycosides, chloramphenicol, macrolides, tetracyclines, and quinolones [Antimicrob Agents Chemother. 2004 Jun;48(6):1921-33]. Ceftriaxone has the best MIC values of all antibiotics tested. In the past chloramphenicol has been used extensively in Perú because of its ability to simultaneously cover concomitant opportunistic salmonellosis. Because of increasing salmonella resistance to chloramphenicol and toxicity concerns with this drug, ciprofloxacin 500 mg po bid for 14 days is now the first line therapy for uncomplicated cases, although clearly almost any available antibacterial agent will suffice for the bartonellosis itself. There are no prospective or randomized treatment trials available. The chronic form is most often treated with azithromycin at present although rifampin has traditionally been used. The bartonella and malaria endemic areas of Perú have little overlap. In a traveler to Perú with fever and anemia, the first diagnosis is malaria if they have been to low lying jungle regions but the first diagnosis should be bartonellosis if travel has been restricted to inter-Andean valleys. Untreated bartonellosis will almost always be fatal in a traveler. Antimalarials are not effective against bartonellosis. Always rule out malaria in a tropical traveler to endemic areas, but it is important not to let a patient with possible bartonellosis die for lack of a little ciprofloxacin or penicillin. |

Discussion: The blood film showed no malaria (altitude of residence is too high anyway) but overall >70% of the red blood cells contained small pleomorphic cocci intracellularly which are diagnostic of acute bartonellosis [Image B, arrows indicate representative intraerythrocytic organisms]. Blood cultures using Columbia agar were ordered but must be incubated at 25-28°C and take up to 2-4 weeks to become positive. On average in bartonellosis, over 60% of erythrocytes have intracellular bacteria. These are most often coccobacilli [see Image E at